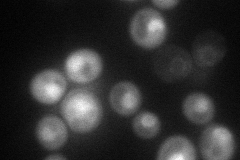
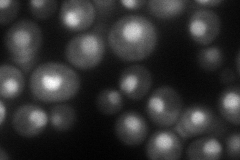
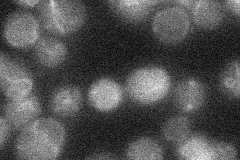
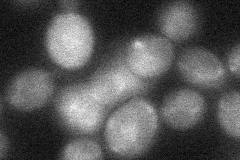
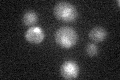

View description
Major component of the proteasome; tethers the proteasome core particle to the regulatory particle, and enhances the stability of the proteasome
Localization:
Intensity:
Fold change:
Significance:
-
C’ GFP library in SD

nucleus:cytosol34.79 -
N' NOP1pr-GFP in SD
cytosol,nucleus88.0055 -
N' TEF2pr-mCherry in SD
nucleus85.8837 -
N' NATIVEpr-GFP in SD
below threshold17.3256 -
N' TEF2pr-VC and Cyto-VN in SD
cytosol30.4224 -
C’ GFP library in SD+DTT

nucleus.cytosol25.920.74No -
C’ GFP library in SD+H2O2

nucleus.cytosol35.711.02No -
C’ GFP library in Starvation Media
nucleus,cytosol22.480.64Yes -
C’ GFP library on the background of Pup2-DaMP

nucleus:cytosol -
C’ GFP library on the background of CCT mutant

nucleus:cytosol43.60581.25306No
